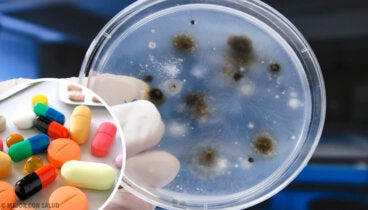
Tratamiento de la aspergilosis

Alejandro Duarte
Equipo médico
BiotecnólogoSobre el autor
Graduado en Biotecnología por la Universidad de León (2017). Está cursando un Máster en Investigación y Comercialización del Medicamento por la Fundación Teófilo Hernando en colaboración con la Universidad Autónoma de Madrid.
Durante 17 meses, estuvo involucrado en distintos equipos de investigación de la Facultad de Ciencias Biológicas de la Universidad de León. Además, ha trabajado en varios laboratorios de análisis clínicos. Así como Content Editor de artículos enfocados en salud y bienestar.
En la actualidad trabaja en IQVIA, organización multinacional dedicada a la realización de ensayos clínicos.
Tiene gran interés por la biomedicina molecular que le llevó a seguir una carrera en investigación clínica.